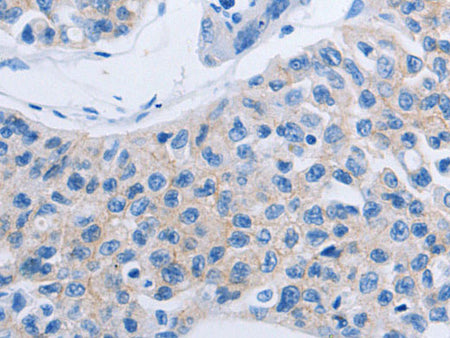
HOXA6 Polyclonal Antibody

HOXA6 Polyclonal Antibody
Couldn't load pickup availability

Still have questions? Ask our experts!
HOXA6 Polyclonal Antibody
| SKU # | E-AB-10369 |
| Reactivity | Human, Mouse |
| Host | Rabbit |
| Applications | IHC |
Product Details
| Isotype | IgG |
| Host | Rabbit |
| Reactivity | Human, Mouse |
| Applications | IHC |
| Clonality | Polyclonal |
| Immunogen | Recombinant protein of human HOXA6 |
| Abbre | HOXA6 |
| Synonyms | HOX 1, HOX1, HOX1.2, HOXA6, HX A6, HXA6, Homeo box 1B, Homeo box A6, Homeobox 1B, Homeobox A6, Homeobox protein Hox A6, Homeobox protein Hox-1B, Homeobox protein Hox-A6, Homeobox protein HoxA6, Hox 1B, Hox1B |
| Swissprot | |
| Cellular Localization | Nucleus. |
| Concentration | 0.3 mg/mL |
| Buffer | Phosphate buffered solution, pH 7.4, containing 0.05% stabilizer and 50% glycerol. |
| Purification Method | Affinity purification |
| Research Areas | Epigenetics and Nuclear Signaling, Developmental Biology |
| Conjugation | Unconjugated |
| Storage | Store at -20°C Valid for 12 months. Avoid freeze / thaw cycles. |
| Shipping | The product is shipped with ice pack,upon receipt,store it immediately at the temperature recommended. |
Related Reagents
| Applications | Recommended Dilution |
| IHC | 1:25-1:100 |
Background
In vertebrates, the genes encoding the class of transcription factors called homeobox genes are found in clusters named A, B, C, and D on four separate chromosomes. Expression of these proteins is spatially and temporally regulated during embryonic development. This gene is part of the A cluster on chromosome 7 and encodes a DNA-binding transcription factor whicHuman, Mouseay regulate gene expression, morphogenesis, and differentiation.